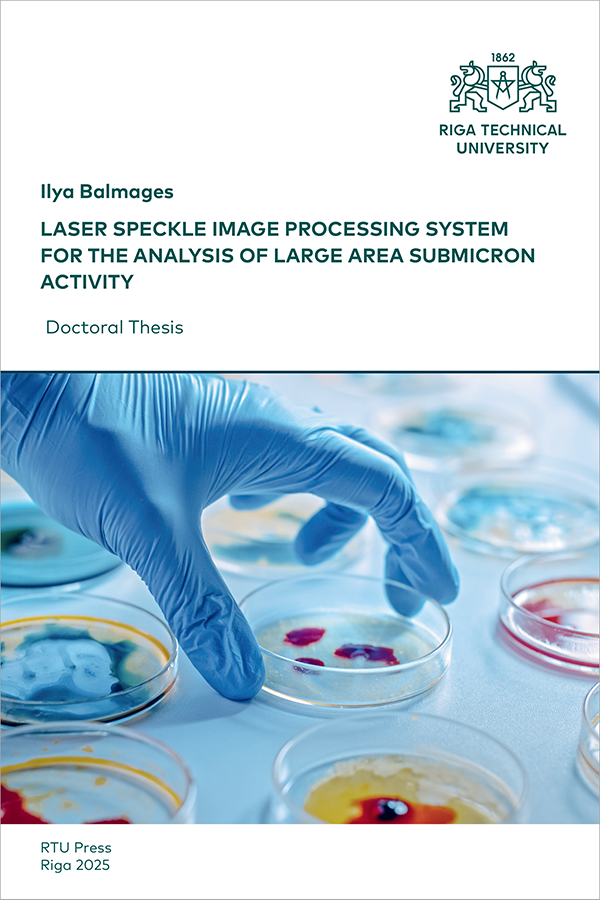

Laser Speckle Image Processing System for the Analysis of Large Area Submicron Activity
Doctoral Thesis
The development of new technologies and data processing algorithms is drawing increasing attention to the field of processing very low-frequency signals. One of the areas is monitoring changes in the growth and inhibition of microorganisms. Optical contactless technology (laser speckle patterns analysis) has been proposed for this aim. The technological advantage lies in the small size of compact equipment and change-sensitive granular structure. The sensitive correlation subpixels algorithm allows the conversion of a speckle image sequence into an array of temporal signals and is capable of highlighting hidden effects. An important advantage of this approach is that any subsequent signal processing algorithms can be applied to the array of obtained signals, such as filtering, operations in the time, frequency, or time-frequency domains, and also use the algorithms of spatial signal processing, analysing the behaviour and changes in the time-spatial domain. The application of artificial neural networks with additional post-processing based on understanding the properties of the signals has yielded high achievements in the classification of growing (active) and inactive zones.
Additional information
| Publication type | |
|---|---|
| Defence date | 22.09.2025. |
| Format | |
| Pages | 121 |
| Publication date | |
| Published online | |
| Publication language | |
| Publisher | RTU Press |
| Country of Publication | Latvia |